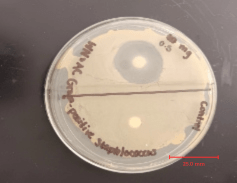

Abstract
This pilot study compared the antimicrobial effects of the acillin compound from crude garlic preparations (a 0.5 mg garlic-infused disc and a garlic-soaked disc) with a 10 μg ampicillin disc against environmental Gram-positive Staphylococcus isolates using the Kirby-Bauer disc diffusion method. Zones of inhibition were measured over four nonconsecutive days, revealing that garlic-soaked discs produced the largest and most persistent inhibition zones (~37–45 mm), followed by 0.5 mg garlic discs (~25 mm), while ampicillin discs showed significantly smaller zones (~10 mm). Control discs showed no inhibition. Although results suggest stronger antimicrobial activity for garlic preparations under these conditions, limitations including unquantified allicin content, dose disparities, lack of biological replicates, and interrupted measurements prevent definitive conclusions. Further research with standardized compounds and expanded replication is needed to confirm garlic’s potential as a complementary antimicrobial agent.
Keywords: allicin, ampicillin, antibiotic resistance, Staphylococcus, Kirby-Bauer method, natural antimicrobials
Introduction
The global rise of antimicrobial resistance (AMR) threatens the ability to treat common bacterial infections, with resistant strains steadily outpacing traditional antibiotics. Ampicillin, once widely effective, is now struggling to combat many pathogens1. As conventional drugs lose ground, there’s an urgent need to explore alternative sources—especially those grounded in natural remedies. Garlic (Allium sativum), a staple in traditional medicine, contains allicin, a sulfur-based compound with well-documented antimicrobial properties2,3. In an era of resistance, garlic may offer a viable, plant-based intervention worth closer examination.
Background
First-line antibiotics are becoming less effective against bacterial strains like Staphylococcus, which is particularly concerning given their prevalence in healthcare and community environments. Estimates suggest that 20–50% of Staphylococcus isolates are already multidrug-resistant4,5. Though several studies confirm allicin’s antimicrobial strength, most focus on purified compounds or clinical isolates, overlooking its impact on bacteria from everyday environments6,7. That’s a gap worth addressing, especially since community-acquired resistance often starts with environmental exposure.
This study compares the antimicrobial effects of two garlic-based preparations—a 0.5 mg garlic-infused disc and a garlic-soaked disc—with a standard 10 μg ampicillin disc. Using Staphylococcus samples collected from high-contact surfaces, the study evaluates garlic’s potential as a cost-effective sanitation method or as a complementary antimicrobial treatment.
Antibiotics
Antibiotics are chemically diverse agents—often derived from fungi or bacteria—that act by either killing bacteria (bactericidal) or inhibiting their growth (bacteriostatic). They generally function through five primary mechanisms:
- Inhibiting cell wall synthesis
- Disrupting protein synthesis
- Interfering with metabolic pathways
- Damaging cytoplasmic membranes
- Inhibiting nucleic acid synthesis
Major antibiotic classes include penicillins, cephalosporins, aminoglycosides, tetracyclines, macrolides, and fluoroquinolones. Broad-spectrum antibiotics target a wide range of pathogens—including Gram-positive, Gram-negative, and anaerobic organisms—whereas narrow-spectrum drugs are more selective. Regardless of scope, antibiotics remain central to modern medicine8.
Antibiotic Resistance
Bacteria develop resistance through mechanisms like gene mutation, enzyme production, and horizontal gene transfer—resulting in strains that standard antibiotics can no longer treat9,5. While antibiotics have revolutionized medicine, enabling surgeries and cancer treatments, rising resistance now jeopardizes those advances. In 2019 alone, AMR caused an estimated 1.27 million deaths and contributed to nearly 5 million more10. Meanwhile, the pipeline for new antibiotics remains critically limited.
Gram-positive Staphylococcus Bacteria
Bacteria come in three basic shapes: cocci (spherical), bacilli (rod-shaped), and spirilla (spiral)11. Gram-positive Staphylococcus—cocci typically found in grape-like clusters—is especially relevant to public health. While commonly found on skin and mucous membranes, it also survives on inanimate surfaces, including soil and fomites1. Its tendency to acquire resistance makes it even more dangerous, with multidrug resistance documented in nearly half of clinical isolates4.
Gram staining helps classify bacteria based on cell wall structure11:
- Gram-positive bacteria have a thick peptidoglycan layer with teichoic acids, staining purple.
- Gram-negative bacteria have a thinner layer and an outer membrane, staining pink.
This structural difference shapes their interactions with host cells and their production of toxins12. For example, Staphylococcus aureus—a notorious Gram-positive pathogen—evolves rapidly through gene mutations and horizontal transfer, making it a treatment challenge1.
Ampicillin
Ampicillin is a β-lactam antibiotic derived from 6-aminopenicillanic acid and designed to expand the antibacterial range of penicillin. It targets bacterial cell walls by binding to penicillin-binding proteins (PBPs), halting peptidoglycan synthesis, and ultimately causing cell lysis. However, resistance has increased significantly, driven largely by β-lactamase enzymes that cleave the β-lactam ring9. Since the 1970s, plasmid-mediated resistance has spread rapidly, with 5–40% of Haemophilus influenzae isolates now resistant to ampicillin8.
Allicin
Allicin is a volatile organosulfur compound formed when garlic is crushed or chopped, catalyzing a reaction between the amino acid alliin and the enzyme alliinase13. It exhibits broad-spectrum antimicrobial effects against bacteria, fungi, viruses, and protozoa by disrupting essential metabolic processes. Specifically, allicin rapidly reacts with thiol-containing enzymes—such as cysteine proteases, alcohol dehydrogenase, thioredoxin reductase, and RNA polymerase—leading to loss of function and inhibited cell growth2,3. Though unstable in its raw form, allicin remains a promising candidate in the search for natural antimicrobial agents, especially as resistance to synthetic drugs increases6.
Rationale
While allicin’s antimicrobial properties are well-documented in clinical settings, far fewer studies explore how practical garlic preparations affect environmental Staphylococcus isolates. These strains—frequently acquired from surfaces in public or shared spaces—play a critical role in the spread of resistance. By comparing garlic-infused and garlic-soaked discs to a standard ampicillin disc, this investigation aims to evaluate garlic’s efficacy in a real-world context. If proven effective, such an approach could inform low-cost sanitation strategies or supplementary treatments in communities disproportionately impacted by AMR.
Methodology
This study employed the Kirby-Bauer disc diffusion method to assess and compare the antimicrobial efficacy of ampicillin (10 μg) and garlic (0.5 mg and garlic-soaked discs) against Staphylococcus bacteria. Bacterial cultures were evenly spread on Mueller-Hinton agar plates, and antimicrobial discs were placed in designated zones (control, ampicillin, 0.5 mg garlic, and garlic-soaked). After incubation, zones of inhibition were measured daily over four nonconsecutive days to evaluate treatment effectiveness. A sterile blank disc served as the negative control, while standardized procedures ensured experimental consistency. Data collection included mm-scale measurements and photographic documentation for comparative analysis.
Objective
The primary objective of this study is to evaluate and compare the antimicrobial efficacy of garlic and ampicillin against Gram-positive Staphylococcus bacteria. The research question addresses which treatment demonstrates greater effectiveness: a 0.5 mg garlic disc, a garlic-soaked disc, or 10 μg ampicillin disc.
Hypothesis
The 0.5 mg garlic disc will be ineffective, the garlic-soaked disc will show slight efficacy, and the 10 μg ampicillin disc will be the most effective against Gram-positive Staphylococcus bacteria.
Results
This lab aimed to preliminarily compare the antimicrobial activity of a 10 μg ampicillin disc, a garlic-soaked disc, and a 0.5 mg garlic disc against environmental Gram-positive Staphylococcus isolates. Due to the lack of biological replicates and statistical analysis, these observations should be interpreted as exploratory trends rather than conclusive evidence.
The 10 mm ampicillin zone diameter falls below the CLSI resistance breakpoint (≤28 mm) for Staphylococcus spp., though this interpretation is provisional without MIC confirmation or control strain validation14.
Based on the data collected, the initial hypothesis, which predicted ampicillin’s superiority, was not supported under these experimental conditions. The results suggest that crude garlic preparations produced larger inhibition zones than ampicillin in this assay; however, methodological constraints (e.g., unquantified allicin, mass-dose disparities) prevent definitive efficacy comparisons.
Inhibition zone measurements across all treatments are presented in the Zone of Inhibition Table. After a four-day observation period, the key observations were as follows: the 10 μg ampicillin disc measured 10 mm, the garlic-soaked disc measured a maximum diameter of 45 mm, the 0.5 mg garlic disc measured 25 mm, and the control disc showed no inhibition (0 mm).
Under these experimental conditions, the garlic-soaked disc showed the largest inhibition zones, followed by the 0.5 mg garlic disc, with the 10 μg ampicillin disc showing the smallest zones. By the end of the observation period, the 10 μg ampicillin disc’s inhibition zone was nearly overtaken by bacterial overgrowth, the 0.5 mg garlic disc exhibited a thin but present bacterial sheen, and the garlic-soaked disc had minimal visible bacterial growth within its inhibition zone—though some bacterial colonies had begun to form.
The observed difference in inhibition zone sizes between the garlic-treated discs and the ampicillin disc could indicate stronger antimicrobial activity under these specific test conditions. While allicin is a likely contributor, the study’s design cannot confirm it as the only one due to unmeasured variables (e.g., allicin degradation, synergistic effects of other garlic compounds). The absence of a control strain (e.g., ATCC 25923) further limits resistance profiling, though the ampicillin zones align with trends seen in environmental Staphylococcus isolates with reduced β-lactam susceptibility1. The structural composition of Gram-positive Staphylococcus bacteria—particularly its peptidoglycan-rich cell wall—may influence susceptibility to garlic-derived compounds, but further studies with purified allicin are needed to isolate mechanisms.
Observations
| Table 1: Zone of Inhibition Table | ||||
|---|---|---|---|---|
| Antibiotics | Day 1 | Day 2 | Day 6 | Day 7 |
| 10 μg Ampicillin | 7.0 mm | 9.0 mm | 10.0 mm | 10.0 mm |
| Garlic-soaked | 50.0 mm (max) / 42.0 mm (min) | 46.0 mm (max) / 40.0 mm (min) | 45.0 mm (max) / 38.0 mm (min) | 45.0 mm (max) / 37.0 mm (min) |
| 0.5 mg Garlic | 26.0 mm | 29.0 mm | 25.0 mm | 25.0 mm |
| Control | 0.0 mm | 0.0 mm | 0.0 mm | 0.0 mm |
Error bars represent the range of measurements for garlic-soaked discs, reflecting the non-circular shape of the inhibition zone. For all other treatments, no error bars are shown because zone diameters were consistent and circular. No statistical comparisons are reported, as the error for garlic-soaked discs does not reflect biological or technical replicates but variability in measured diameter due to irregular zone geometry.
Data Analysis
Day 1:
Disregarding the inhibition zones, bacterial “lawn” growth was present on both Agar plates. The 10 μg ampicillin disc had a relatively small inhibition zone of 7 mm. The 0.5 mg garlic disc had an inhibition zone of 26 mm, and the garlic-soaked disc had an inhibition zone of 50 mm. The zone of inhibition grew in a circle around both the 10 μg ampicillin disc and 0.5 mg garlic disc. However, the zone of inhibition around the garlic-soaked disc was not circular but rather an area in which bacteria growth was barely present, with the exception of a few colonies around the division area.
Day 2:
In areas previously unaffected by antimicrobial activity, the bacterial “lawn” maintained a steady growth on both Agar plates. The 10 μg ampicillin disc had an increased inhibition zone of 9 mm. However, a few small colonies of bacteria began to encroach into the inhibition zone. The zone of inhibition around the 0.5 mg garlic disc increased to 29 mm, but a faint ring of bacteria began growing around the edge of the inhibition zone. The garlic-soaked disc’s inhibition zone decreased to 46 mm, and bacteria began to grow around the edges of the inhibition zone. Both the 0.5 mg garlic and 10 μg ampicillin disc maintained a circular inhibition zone, while the garlic-soaked disc’s inhibition zone did not have any specific shape.
Day 3:
No observations were recorded.
Day 4:
No observations were recorded.
Day 5:
No observations were recorded.
Day 6:
After a 3-day period of no observations, the bacterial “lawn” continued to grow steadily. The 10 µg ampicillin disc’s inhibition zone increased to 10 mm. However, a ring of bacteria began to grow around the disc. The 0.5 mg garlic disc’s inhibition zone decreased to 25 mm. A thin layer of bacteria began to grow over the inhibition zone. The garlic-soaked disc’s zone of inhibition decreased to 45 mm. Small colonies began to dot around the inhibition zone, but the bacterial lawn remained at a similar distance. All the antibiotics retained the same zone of inhibition shapes as previously recorded.
Day 7:
The bacterial “lawn” and zones of inhibition remained relatively unchanged. The 10 μg ampicillin disc’s inhibition zone remained at 10 mm. However, antimicrobial activity was nearly undetectable as the bacterial ring surrounding the disc grew. The 0.5 mg garlic disc also retained an unaffected inhibition zone of 25 mm. The thin layer of bacteria covering the disc appeared to have undergone little growth. The garlic-soaked disc maintained an inhibition zone of 45 mm. The bacterial “lawn” did not encroach any further; however, more small colonies within the inhibition zone appeared. All of the antibiotics retained the same zone of inhibition shapes as previously recorded.
Discussion
Limitations
The study faced several limitations and potential sources of error that may have influenced the findings. Reliance solely on disc diffusion assays precludes determination of minimum bactericidal concentrations (MBCs) and time-kill kinetics. Disc diffusion measures antimicrobial potency and diffusion but cannot distinguish whether an agent is bacteriostatic (inhibits growth) or bactericidal (kills bacteria). Therefore, it remains unclear whether the observed inhibition zones reflect true bacterial killing or merely growth inhibition. Furthermore, resource constraints prevented technical replicates and data collection was interrupted for three consecutive days (days 3–5) due to lack of laboratory access, limiting assessment of non-linear changes in antimicrobial activity despite consistent plate storage.
Additionally, while the bacterial culture was initially cultivated as a pure sample and verified twice before experimentation, no purity check was conducted after the slant process, raising the possibility of contamination or deviation from the intended Staphylococcus species.
The concentration of allicin in the garlic-soaked discs was not quantified, making it difficult to determine the exact dosage used or compare its effects directly with those of antibiotics. Without chemical verification (e.g., HPLC) of allicin content at the time of disc application and post-incubation, the observed inhibition zones may reflect variable or degraded doses rather than stable pharmacodynamic effects. Furthermore, the three-orders-of-magnitude mass difference between treatments (milligrams of garlic versus micrograms of ampicillin) was chosen to evaluate real world applicability. However, it fundamentally limits direct comparisons of antimicrobial potency. Although the distilled water was stored in a sanitary container, not cross-contaminated during the study, and sterile-filtered prior to use, sharing water among multiple research groups could pose a potential risk of contamination.
A solvent control (sterile water–soaked disc) was not included, so the potential contribution of water saturation to the observed inhibition zones around garlic-soaked discs cannot be ruled out. The study also did not include MIC or broth dilution testing, nor a known sensitive control strain such as Staphylococcus aureus ATCC 25923, due to resource constraints. As a result, resistance interpretations based solely on disc diffusion zone diameters are provisional
The study’s statistical power is limited by the use of single-measurement inhibition zones from three plates without biological replicates (independent cultures). While consistent trends were observed across plates, the absence of standard deviations and formal significance testing (e.g., ANOVA/Kruskal-Wallis) prevents definitive claims about treatment efficacy.
Ampicillin and allicin also have fundamentally different antimicrobial mechanisms. Ampicillin, a β-lactam antibiotic, inhibits bacterial cell wall synthesis by targeting penicillin-binding proteins, leading to cell lysis15. In contrast, allicin disrupts bacterial metabolism by reacting with thiol groups in enzymes critical to cellular function, such as cysteine proteases and RNA polymerase2,3. These distinct actions influence their efficacy and resistance profiles. Therefore, direct comparisons of antimicrobial potency must consider these pharmacodynamic differences.
Manual measurement with a standard ruler introduces ±1 mm variability, proportionally significant for smaller zones. Furthermore, environmental factors such as temperature, pH, antibiotic stability, diffusion rate, and incubation time were not rigorously controlled, limiting the ability to assess their precise impact on bacterial growth and antibiotic efficacy. Another limitation was the imbalance in treatment quantities, as significantly less ampicillin (μg-sized discs) was used compared to garlic, potentially skewing comparative analysis.
Implications
Preliminary findings suggest garlic may have potential as a complementary antimicrobial agent. The consistent inhibition patterns across plates, despite the small sample size, warrant further investigation. Notably, garlic’s antibacterial properties appear effective even without the cultivation and extraction of its active allicin compounds, making it readily available and accessible. Despite the observation gap, the consistency between measurements suggests treatment effects remained stable throughout the experiment. Given that ampicillin belongs to the penicillin family, the observed activity of garlic against this environmental isolate warrants further investigation to determine whether similar effects would be seen against clinically relevant penicillin-resistant strains, such as MRSA.
If further studies confirm garlic’s efficacy on both Gram-positive and Gram-negative bacteria, it could play a larger role in addressing antibiotic resistance on a global scale. Additionally, the possibility of cultivating allicin compounds into a more standardized medicinal form could enhance its application in clinical settings.
While the observed inhibition zones suggest garlic-derived compounds may inhibit Staphylococcus growth, the study’s limitations (e.g., crude preparations, unmeasured allicin degradation) prevent extrapolation to clinical applications. It is important to note that larger inhibition zones in vitro do not necessarily translate to clinical efficacy, as factors such as pharmacokinetics, achievable tissue concentrations, and host toxicity are not addressed in this assay. Crude garlic preparations contain additional plant components and volatile compounds that are unlikely to reach therapeutic levels systemically, and the safety profile of such treatments in vivo remains uncharacterized. Studies have shown that allicin is rapidly metabolized after ingestion, and neither allicin nor its transformation compounds are typically detected in blood or urine, with serum levels far below the MICs reported in vitro for most pathogens16,10. Therefore, these findings should not be interpreted as evidence of pharmaceutical-level efficacy for garlic, and recommend that future studies compare achievable allicin serum concentrations to published MIC values, as well as assess bioavailability and safety in relevant models.
Future Recommendations
To validate and expand upon these preliminary findings, future research should prioritize standardized antimicrobial preparations, including HPLC quantification of allicin, mass-normalized dosages, and membrane filtration (0.22 μm) of garlic extracts to ensure sterility. A sterile water–soaked disc should also be included to isolate potential diffusion effects unrelated to allicin.
Experimental designs should incorporate biological replicates and technical replicates analyzed via one-way ANOVA with appropriate post-hoc testing. Precision measurements using image analysis software (e.g., ImageJ), along with daily time-lapse monitoring, would improve temporal and spatial accuracy of inhibition zones. Confirmatory identification of isolates through 16S rRNA sequencing is also recommended.
Existing studies using purified allicin report minimum inhibitory concentrations (MICs) against Staphylococcus aureus in the range of 16–32 μg/mL, with minimum bactericidal concentrations (MBCs) between 128–256 μg/mL17. In contrast, this study observed inhibition zones as large as 45 mm using unquantified crude garlic. This discrepancy may be due to the higher crude mass applied, synergistic activity from additional garlic compounds, or variability in allicin degradation.
Future research should include broth microdilution and time-kill kinetic assays to quantify MIC and MBC values from garlic preparations, allowing direct comparison to published allicin efficacy metrics. These additions would clarify potency and support more reliable translational conclusions.
Ethical Considerations
This study was conducted with careful attention to ethical practices in laboratory research, biosafety, and environmental responsibility. All work with potential Staphylococcus aureus was conducted under Biosafety Level 2 (BSL-2) conditions in accordance with local and institutional biosafety guidelines for high school laboratories. Personal protective equipment, including disposable gloves and safety goggles, was worn at all times. Work surfaces were disinfected before and after procedures, and all tools were flame-sterilized. Biological waste and cultures were autoclaved prior to disposal to ensure complete decontamination. The project received approval and oversight from the school’s science department and adhered to all relevant institutional and district safety protocols. Antibiotic use was minimized by employing only small, standardized quantities of ampicillin (10 μg discs) to reduce environmental impact while still maintaining experimental validity.
Transparency and data integrity were prioritized throughout the process. All limitations were documented to ensure the findings are interpreted appropriately. Measurements of inhibition zones were taken objectively using calibrated tools, and raw data was preserved to support reproducibility. While the results suggest garlic’s potential as an antimicrobial alternative, it must be emphasized that these are preliminary findings requiring further validation before any clinical applications could be considered.
By focusing on environmental bacterial isolates rather than clinical strains, ethical concerns associated with human samples were avoided while still contributing meaningful data to the broader discussion on antibiotic resistance. Ultimately, this study’s approach balanced scientific inquiry with responsible research practices, aligning both academic standards and public health priorities in the fight against antimicrobial resistance.
Methods
Study Design
This experiment uses the Kirby-Bauer disc diffusion method to compare the antimicrobial effectiveness of ampicillin and garlic. The Kirby-Bauer method is a test used to determine the sensitivity or resistance of bacteria to a specific antimicrobial agent. During this test, bacteria is spread evenly through a Mueller-Hinton Agar plate, then antibiotic discs are placed and left to incubate. After 24 hours or more, the plates are observed and measured for a zone of inhibition. After inoculation and disc placement, all plates were incubated at 25 °C (±1 °C) for at least 24 h prior to each observation. Following each measurement, plates were returned to the incubator and maintained at 25 °C (±1 °C) until the next observation. Zone diameters were measured to the nearest mm using a standard ruler. For irregular zones around garlic-soaked discs, both maximum and minimum diameters were recorded (provided in the Zone of Inhibition Table), though single values were used for consistency in primary analysis. The larger the zone displays the more effective the antimicrobial agent, and no zone of inhibition indicates bacterial resistance.
Antimicrobial testing followed CLSI M02-A13 (2023) guidelines for single-concentration disc diffusion screening. The 10 μg ampicillin disc was selected as the standardized reference for Gram-positive bacteria, with zone diameters interpreted against CLSI breakpoints (susceptible ≥29 mm; resistant ≤28 mm)14. While control strains (e.g., S. aureus ATCC 25923) were not included due to resource constraints, all isolates underwent triple Gram-stain verification and exhibited consistent morphologies.
Garlic-soaked discs were prepared by: surface-sterilizing whole cloves with 70% ethanol for 30 seconds, aseptically crushing and immediately transferring paste to sterile containers, soaking blank discs for 10 minutes at room temperature, and (4) removing excess liquid before application. Control discs underwent identical soaking in sterile water.
The independent variables are the types of antimicrobial agents tested: a 10 μg ampicillin disc, a garlic-soaked disc, and a 0.5 mg garlic disc. The dependent variable is the size of the zone of inhibition, which indicates how effectively each agent inhibits bacterial growth.
The experiment is controlled by using a blank paper-disc without any antimicrobial agents, ensuring that any observed effects result from the treatments. Commercial ampicillin disks (10 μg) used in this study were verified to meet CLSI purity standards to ensure the potency and reliability of the antimicrobial agent. The agar plate is divided into four labeled zones (Control, 10 μg of Ampicillin, 0.5 mg Garlic, Garlic-Soaked) so that the effects of each treatment can be observed simultaneously under identical conditions.
Materials
- 3 agar plates
- Bacterial slant containing Gram-positive Staphylococcus bacteria
- Inoculating loop
- Safety goggles
- Bunsen burner
- Gas inlet
- Matches
- Spreader
- Distilled water
- Ampicillin 10 μg disc
- 3 blank paper-discs
- 1 garlic clove
- Grater
- Glass jar
- Pipette
- Tweezers
- Sharpie
Procedure
Gather all necessary supplies and clean the lab station thoroughly. Put on safety goggles for protection and prepare the Bunsen burner. Sterilize the inoculation loop in the flame and allow it to cool. Flame the outside of the slant tube near the top. Use the inoculation loop to collect bacteria from the slant. Before sealing the slant tube, flame its opening again. Using the streak plate method, transfer the bacteria onto one Agar plate. Allow the bacteria to cultivate. Using the inoculation loop, place a pure culture onto a new Agar plate. Pour a small amount of distilled water on top of the bacteria. Sterilize the spreader in the flame and evenly spread the bacteria across the plate in a circular motion. Repeat the bacteria injection and spread on another Agar plate. Cover each plate with its lid and label it with the name, category of bacteria, and date.
Divide one of the plates into two zones with a Sharpie, labeling them “Garlic-Soaked.” and “Ampicillin.” Divide the other plate into two zones, labeling them “0.5 mg Garlic” and “Control.” Sterilize tweezers in the flame and allow them to cool before placing the ampicillin disc in the corresponding labeled zone.
Grate a garlic clove into a glass jar. Use a pipette to measure 0.5 mg of minced garlic and squeeze it onto a blank disc. Use sterilized tweezers to place the garlic disc in its labeled zone. Sterilize the tweezers again and soak another blank tablet in the jar of grated garlic until fully saturated. Use the tweezers to place the soaked disc in the corresponding labeled zone. Sterilize the tweezers and allow them to cool before placing a blank disc in the control zone. To limit the loss of allicin activity due to its instability, the time elapsed from garlic grating to disk placement was kept to approximately 1 minute and 30 seconds, and this timing should be maintained in subsequent reproductions of this experiment.
Finally, place the Agar plates in the incubator and allow the bacteria to cultivate. Observe the plates and measure the zone of inhibition around each tablet in millimeters.
Data Collection Technique
The zones of inhibition around each tablet were measured daily using a mm ruler. These measurements were taken by observing and recording the diameter of the clear areas where bacterial growth was prevented.
The measurements were recorded for four nonconsecutive days to monitor any changes in the inhibition zone’s diameter. A table was used to log the data, categorizing the results by day and treatment type. A line plot graph, bar graph, and image documentation were also used to record data. This setup ensured accurate, consistent data collection and made it easier to compare the effectiveness of each antimicrobial agent.
Conclusion
This pilot study demonstrates that crude garlic preparations can inhibit environmental Staphylococcus isolates under controlled conditions. However, the methodological limitations highlighted herein—particularly the lack of allicin quantification and dose normalization—necessitate cautious interpretation. These preliminary findings justify further investigation with purified compounds and rigorous pharmacokinetic analysis.
Acknowledgements
The authors of this paper would like to express sincere gratitude to Glide High School’s microbiology teacher Mr. Shaw for his invaluable guidance, support, and expertise throughout this research project. His mentorship was instrumental in shaping the experimental design and refining methodology.
The authors also extend appreciation to Glide High School’s microbiology lab for providing the necessary equipment and resources to conduct this study. Special thanks to peers for their constructive feedback during the research process.
Finally, the authors acknowledge the contributions of previous researchers whose work on antimicrobial resistance, allicin, and ampicillin provided the foundational knowledge that informed the investigation.
References
- F. D. Lowy. Staphylococcus aureus infections. New England Journal of Medicine 339, 520–532 (1998). https://doi.org/10.1056/NEJM199808203390806. [↩] [↩] [↩] [↩]
- S. Ankri, D. Mirelman. Antimicrobial properties of allicin from garlic. Microbes Infect. 1, 125–129 (1999). [↩] [↩] [↩]
- J. Borlinghaus, F. Albrecht, M. C. H. Gruhlke, I. D. Nwachukwu, A. J. Slusarenko. Allicin: Chemistry and biological properties. Molecules 19, 12591–12618 (2014). https://doi.org/10.3390/molecules190812591. [↩] [↩] [↩]
- M. Vestergaard, D. Frees, H. Ingmer. Antibiotic resistance and the MRSA problem. Microbiol Spectr. 7 (2019). https://doi.org/10.1128/microbiolspec.gpp3-0057-2018. [↩] [↩]
- F. Prestinaci, P. Pezzotti, A. Pantosti. Antimicrobial resistance: a global multifaceted phenomenon. Pathogens and Global Health 109, 309–318 (2015). https://doi.org/10.1179/2047773215Y.0000000030. [↩] [↩]
- A. Marchese, R. Barbieri, E. Coppo, I. E. Orhan, M. Daglia, S. F. Nabavi, S. M. Nabavi. Antifungal and antibacterial activities of allicin: A review. Trends Food Sci Technol. 52, 49–56 (2016). https://doi.org/10.1016/j.tifs.2016.03.010. [↩] [↩]
- J. C. Harris, S. Cottrell, S. Plummer, D. Lloyd. Antimicrobial properties of Allium sativum (garlic). Appl Microbiol Biotechnol. 57, 282–286 (2001). https://doi.org/10.1007/s002530100722. [↩]
- C. L. Ventola. The antibiotic resistance crisis: part 1: causes and threats. P & T 40, 277–283 (2015). https://www.ncbi.nlm.nih.gov/pmc/articles/PMC4378521/. [↩] [↩]
- S. M. Drawz, R. A. Bonomo. Three decades of β-lactamase inhibitors. Clinical Microbiology Reviews 23, 160–201 (2010). https://doi.org/10.1128/CMR.00037-09. [↩] [↩]
- CDC (U.S. Centers for Disease Control and Prevention). Antibiotic resistance threats in the United States, 2022. https://www.cdc.gov/drugresistance/biggest-threats.html (2022). [↩] [↩]
- T. J. Silhavy, D. Kahne, S. Walker. The bacterial cell envelope. Cold Spring Harb Perspect Biol. 2, a000414 (2010). https://doi.org/10.1101/cshperspect.a000414. [↩] [↩]
- T. J. Beveridge. Structures of Gram-negative cell walls and their derived membrane vesicles. Journal of Bacteriology 181, 4725–4733 (1999). https://doi.org/10.1128/JB.181.16.4725-4733.1999. [↩]
- A. Rabinkov, T. Miron, L. Konstantinovski, M. Wilchek, D. Mirelman, L. Weiner. Alliin lyase (alliinase) from garlic (Allium sativum). Appl Biochem Biotechnol. 48, 149–171 (1994). https://doi.org/10.1007/bf02788739. [↩]
- CLSI (Clinical and Laboratory Standards Institute). Practical tips for antimicrobial susceptibility testing (AST) news update. CLSI News. https://clsi.org/about/news/ast-news-update-2019-practical-tips-2/ (2019). [↩]
- T. J. Silhavy, D. Kahne, S. Walker. The bacterial cell envelope. Cold Spring Harb Perspect Biol. 2, a000414 (2010). https://doi.org/10.1101/cshperspect.a000414. [↩]
- L. D. Lawson, Z. J. Wang. Allicin bioavailability and bioequivalence from garlic supplements and garlic foods. Nutrients 10, 812 (2018). https://doi.org/10.3390/nu10070812. [↩]
- R. R. Cutler, P. Wilson. Antibacterial activity of a new, stable, aqueous extract of allicin against methicillin-resistant Staphylococcus aureus. Br J Biomed Sci. 61, 71–74 (2004). https://doi.org/10.1080/09674845.2004.11732646. [↩]